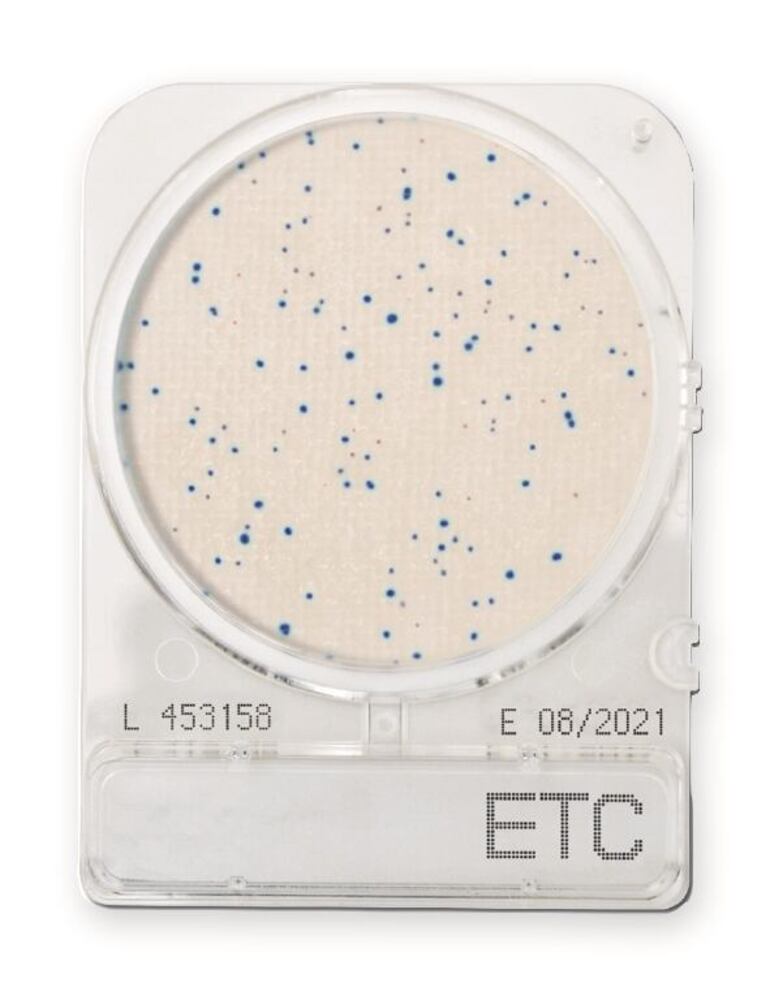
33PH.2, Shimadzu

Products Found:
131
Showing Results For: Ready-Made Media
Ready-Made Media
FILTERS
Filters
Clear All